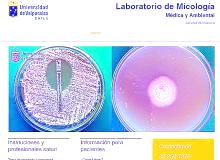

Más leídas

Actualidad | Pág. 2
Con demoras en el ingreso, pero sin incidentes, jóvenes dieron pruebas atrasadas

Opinión | Pág. 13
Comentarios en la web

Actualidad general | Pág. 11
Laboratorios UV
Opinión | Pág. 12
Frases

Opinión | Pág. 12
Ideas fundamentales para un año crucial
Opinión | Pág. 12
EE.UU. envía a Rusia a los descontentos
Opinión | Pág. 12
Una tragedia que no debe olvidarse
Opinión | Pág. 13
En Twitter: #Kobe Bryant

Opinión | Pág. 13
Enfoque
Opinión | Pág. 13
Correo
Servicios | Pág. 16
Recordando a José Martí

Actualidad general | Pág. 11
CIB-UV

Deportes | Pág. 17
Antofagasta cayó ante Santiago en segundo duelo del Nacional de Sóftbol

Deportes | Pág. 17
Récord de puntos en un partido de la NBA

Deportes | Pág. 17
Kobe Bryant, los números que lo convierten en una leyenda de la NBA

Deportes | Pág. 18
ANFP toma medidas tras falla del VAR en Estadio Santa Laura

Deportes | Pág. 18
Colo Colo debutaría con Paredes y sin los lesionados Blandi y Fernández

Deportes | Pág. 18
Inter de Milán se fija en Aránguiz mientras asegura a Christian Eriksen

Deportes | Pág. 18
Rafael Nadal mostró su solidaridad con Nicolás Jarry por caso dopaje
Espectáculos | Pág. 19
Silvio Rodríguez acusa a Orishas de "parasitismo"

Espectáculos | Pág. 19
"A todo o nada": la propuesta veraniega de TVN conducida por Gustavo Huerta

Actualidad general | Pág. 11
Enfermedades por alimentos: ¡cuidado con lo que comes!
Actualidad general | Pág. 10
Trump niega haber dicho a Bolton que condicionó la ayuda militar a Ucrania

Actualidad | Pág. 2
Cruch estima que el 98% rindió la PSU y mañana se informará sobre rezagados

Actualidad | Pág. 6
Loro tricahue recuperado por la PDI estuvo ocho años encerrado

Actualidad | Pág. 2
Calama también vivió una tranquila jornada de rendición
Actualidad | Pág. 2
Tildan como "impresentable" intento de boicot y piden anular el actual proceso

Actualidad | Pág. 4
"Nosotros no vamos a decaer. Estamos más fuertes que nunca y lo hemos demostrado"

Actualidad | Pág. 5
4 millones de pasajeros viajaron por los aeropuertos de la región

Actualidad | Pág. 5
Diputada pide revisar legalidad de prórroga del TransAntofagasta
Actualidad | Pág. 5
Subsecretario del MOP inspeccionó obras de emergencia por las lluvias altiplánicas

Actualidad | Pág. 6
Abren periodo de postulación a becas de la Cámara de la Construcción
Actualidad | Pág. 6
GNL Mejillones inaugura estación de carga para camiones cisterna

Actualidad | Pág. 6
Ingresos de extranjeros por la región descendió 15% en 2019

Actualidad | Pág. 7
Juez amplió detención de sujeto imputado por abuso de menores
Actualidad general | Pág. 10
Talibanes se atribuyen el derribo de un avión militar estadounidense en Afganistán

Actualidad | Pág. 7
Turismo: sólo las Termas de Puritama y el Valle del Arcoiris continúan cerrados

Actualidad | Pág. 7
Premian a jóvenes privados de libertad por sus obras literarias

Actualidad general | Pág. 8
Bancos elevaron los requisitos a créditos de consumo e hipotecarios

Actualidad general | Pág. 8
Suprema mantiene a Emiliano Arias en el Ministerio Público

Actualidad general | Pág. 9
Dólar se dispara más de $13 y toca su mayor nivel en casi dos meses

Actualidad general | Pág. 9
Servel publica padrón para el plesbiscito: hay 14 millones habilitados

Actualidad general | Pág. 9
"Rechazo": Mellado refuta a Desbordes afirmando que podría trabajar con Kast
Actualidad general | Pág. 10
Bolivia: ministros de Áñez comienzan a presentar renuncias
Actualidad general | Pág. 10
China reporta primera muerte por coronavirus en su capital

Contraportada | Pág. 20
Extranjeros residentes tuvieron su fiesta en la plaza Nicolás Tirado